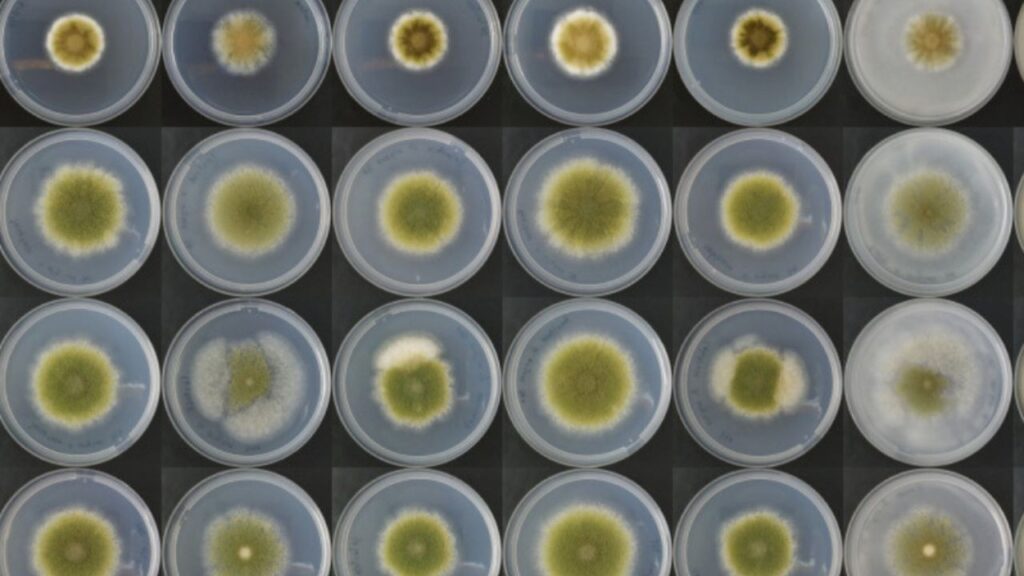
Fungos ganham protagonismo no futuro da alimentação

Durante muito tempo, o protagonismo das proteínas animais foi inquestionável no cenário alimentar global. Entretanto, à medida que cresce a preocupação com as mudanças climáticas, a pressão sobre os recursos naturais e a busca por soluções mais éticas e sustentáveis, uma nova fronteira alimentar começa a ganhar corpo — ou melhor, micélio. Trata-se da base estrutural dos fungos, que agora é cultivada em laboratório e transformada em micoproteínas de alto valor biológico, capazes de substituir com eficiência ingredientes de origem animal.
Essas proteínas fúngicas são resultado de um processo chamado fermentação de precisão, no qual fungos filamentosos ou leveduras são cultivados em condições controladas, alimentando-se de substratos ricos e produzindo estruturas ricas em proteínas e fibras. O que antes era um elemento quase invisível na cadeia biológica agora ocupa o centro da inovação alimentar global.
Da fermentação ao avanço tecnológico
O processo de criação das micoproteínas não depende de grandes áreas agrícolas, tampouco de animais. Com técnicas de biotecnologia como CRISPR/Cas9 e engenharia genética avançada, pesquisadores desenvolvem cepas de fungos capazes de gerar proteínas com textura e sabor semelhantes à carne, mas com uma pegada ambiental drasticamente menor. Além disso, as fábricas celulares fúngicas demandam pouca água, evitam o desmatamento e reduzem consideravelmente a emissão de gases de efeito estufa.
A fermentação submersa, uma das técnicas mais usadas nesse processo, permite o crescimento rápido e controlado do micélio, com eficiência superior à produção tradicional de alimentos. Apesar de consumir energia, principalmente para controle de temperatura e aeração, o impacto ambiental ainda é inferior ao da pecuária intensiva.
Barreiras à consolidação no mercado
Mesmo com os avanços tecnológicos e o interesse crescente da indústria alimentícia, o caminho para as micoproteínas se tornarem comuns na mesa do consumidor ainda exige superação de desafios técnicos e regulatórios. A estrutura do micélio apresenta baixa solubilidade, o que dificulta sua aplicação em alimentos líquidos. Além disso, sua composição rica em fibras exige ajustes na formulação de produtos para que sejam palatáveis e nutricionalmente balanceados, especialmente em dietas infantis ou de idosos.
A digestibilidade das proteínas derivadas de fungos ainda é alvo de estudo, assim como sua alergenicidade potencial, já que algumas reações adversas foram registradas por consumidores de produtos à base de micélio. Para obter aprovação regulatória em larga escala, é necessário garantir padrões rígidos de segurança, controlar possíveis contaminantes como metais pesados e definir limites de consumo.
Ainda que órgãos como a FDA (agência americana de controle de alimentos) tenham aprovado o uso das micoproteínas desde 2001, muitos países ainda tratam esses produtos como “novos alimentos” e exigem análises clínicas robustas antes de liberá-los ao mercado em escala.
Um mercado em plena expansão
A despeito dos obstáculos, o potencial econômico das micoproteínas tem atraído investimentos bilionários. Em cinco anos, o setor já superou até mesmo a carne cultivada em células, arrecadando mais de €628 milhões em aportes globais, contra €459 milhões do setor concorrente. Empresas como Quorn, Meati e The Better Meat Co. lideram esse movimento com produtos que vão desde hambúrgueres até linguiças vegetais, utilizando proteínas derivadas do micélio com teor proteico entre 45% e 48%.
Esse tipo de ingrediente também tem sido explorado em produtos híbridos, que mesclam proteína animal ou vegetal com micélio, aumentando a aceitação entre o público não vegano. Algumas marcas já testam iogurtes, queijos e até alternativas a laticínios com base fúngica — um indicativo de que o uso do micélio vai muito além do segmento de carnes vegetais.
Projeções recentes apontam que o mercado global de micoproteínas deve atingir a marca de US$ 32,3 bilhões até 2032, com taxas de crescimento superiores a 10% ao ano. O setor de substitutos de laticínios baseados em fungos também se mostra promissor, com expectativas de expansão ainda mais acelerada.
Nutrição promissora, mas com ressalvas
As micoproteínas oferecem perfil nutricional interessante, fornecendo aminoácidos essenciais, fibras alimentares e minerais como zinco e selênio. Apesar disso, ainda não entregam vitamina B12 ou ferro em níveis satisfatórios, o que limita seu uso como única fonte proteica em dietas vegetarianas ou veganas restritivas.
Pesquisas clínicas demonstram que seu consumo pode auxiliar na redução de colesterol, controle glicêmico e saciedade, além de estimular a síntese proteica muscular. Contudo, a necessidade de estudos mais amplos sobre seus efeitos de longo prazo persiste — especialmente para grupos mais sensíveis.
Entre inovação e transição alimentar
O uso do micélio como ingrediente funcional é, acima de tudo, uma proposta de transição. Não se trata de substituir integralmente a carne, mas de oferecer alternativas inteligentes, sustentáveis e tecnológicas que ajudem a diversificar a dieta e aliviar a pressão sobre o meio ambiente. Ao integrar essas proteínas aos sistemas alimentares já existentes, é possível fortalecer a segurança alimentar global e construir um modelo mais resiliente frente às crises climáticas.
Afinal, o reino dos fungos, por muito tempo ignorado, pode ser o aliado silencioso de uma nova era da nutrição — mais eficiente, ética e sustentável.
⚠️ Aviso informativo / de contexto científico
As ideias e perspectivas apresentadas neste artigo referem-se a pesquisas emergentes e propostas tecnológicas em fase de desenvolvimento.
Fungos têm grande potencial como fonte de proteína, fermentações alternativas e ingredientes inovadores, mas seu uso em larga escala na alimentação ainda depende de estudos, regulamentações, garantia de segurança e aceitação de mercado.
Os dados e exemplos citados são condicionais — resultados reais podem variar conforme espécie, substrato, processo tecnológico e exigências sanitárias.